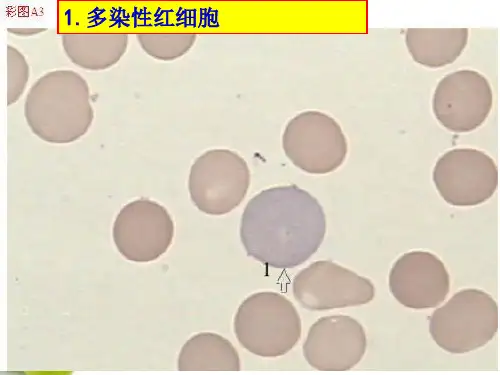

精品医学ppt
29
早幼粒细胞
精品医学ppt
30
中性中幼粒细胞
早幼粒细胞出现特异性颗粒,即为中幼粒细胞.体积 渐变小.由于其有无核小体的不同. 可分为I,II两型.
胞体 椭圆或类圆形,直径15-20微米. 胞核 偏于一侧.多为椭圆形. 染色质 紫红色,呈粗粒网状排列. 核小体 可有1至数个.[I型] 胞质 量多.但核质比仍大于0.5,呈淡兰色,近核处出
网状. 核小体 1-2个,小而明显,呈淡兰色或无色,核膜清楚. 胞质 极少,像一条兰色或天兰色的狭带绕于核周.
近核处有一透明区.核周界明显. 无颗粒.
精品医学ppt
58
原始淋巴细胞
精品医学ppt
59
幼稚淋巴细胞
胞体 园或椭园形,体积与原淋巴细胞相似. 胞核 园,偶有小的凹陷.如鸡心样. 染色质 粗糙,较紧密. 核小体 模糊不清或消失. 胞质 稍多,淡天兰色,偶有少些园形,边缘整
精品医学ppt
2
概述 1
1骨髓是一种海绵状,胶状,脂肪性的组织,封 闭于坚硬的骨髓腔内.成人骨髓的重量为 1650G-3748G,占体重的3.4-5.9%.平均4.6%.骨 髓分为红骨髓和黄骨髓.人初生时,红骨髓充 满全身骨髓腔.随着年龄的增长,渐渐出现黄 骨髓,从远处开始向心性发展.到成人,红骨髓 退到肱骨的上1/3和股骨的上1/3.而颅骨,胸 骨,肋骨,肩胛骨,脊椎及髂骨仍是红骨髓.红骨 髓重量约1000G.红骨髓是主要的造血器官.
齐,直径0.3-0.6微米的黑色嗜天青颗粒.一般 仅有数粒,少数幼稚淋巴细胞超过10粒.
精品医学ppt
60
幼稚淋巴细胞
精品医学ppt
61
淋巴细胞
胞体 圆形直径5-18微米.